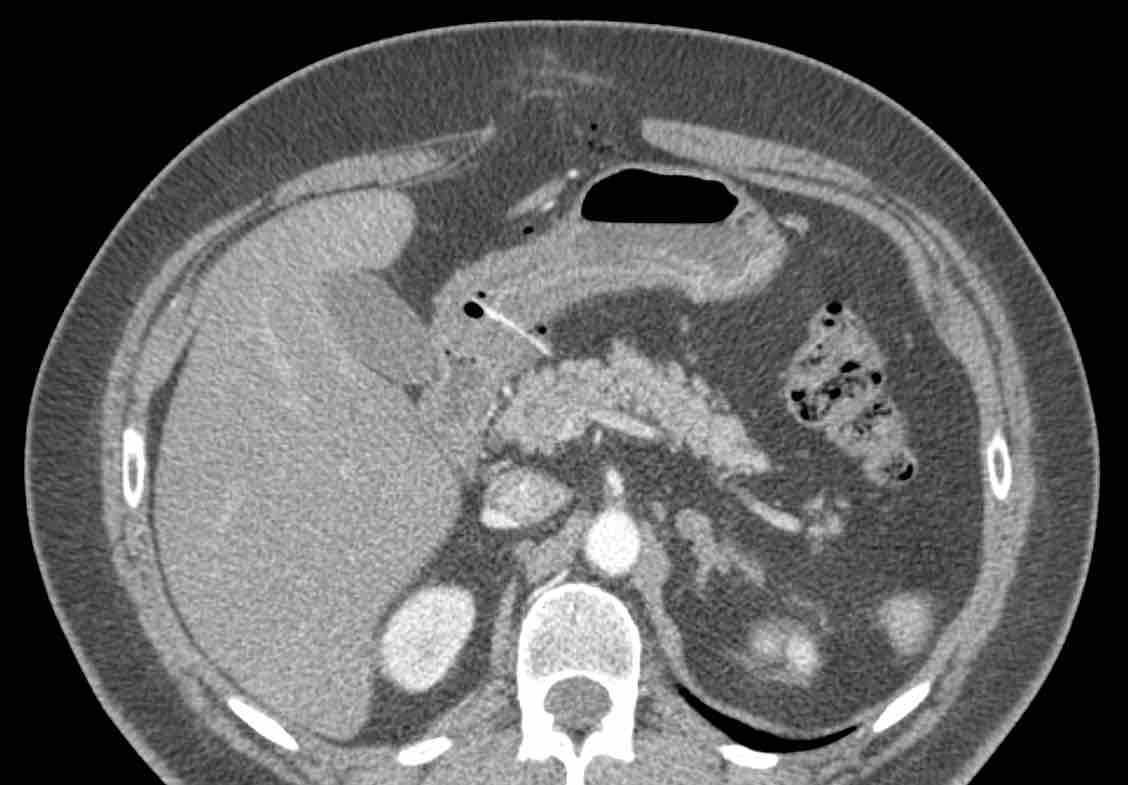

Dị vật sắc nhọn trong đường tiêu hóa
Đây là tổng quan về các hình ảnh siêu âm và CT đa dạng của dị vật sắc nhọn xuyên thủng thành dạ dày hoặc ruột.
Bài viết minh họa này được xây dựng dựa trên tổng quan y văn và kinh nghiệm thực tế của chúng tôi với 49 trường hợp, nhằm giúp bạn đưa ra chẩn đoán chính xác, hiểu được diễn tiến tự nhiên của bệnh, đồng thời hỗ trợ các bác sĩ lâm sàng lựa chọn phương pháp điều trị tối ưu và ít xâm lấn nhất.
Mọi ý kiến đóng góp và nhận xét bổ sung xin gửi về: j.puylaert@gmail.com
Giới thiệu
Nuốt phải dị vật sắc nhọn một cách vô tình là một tình huống có thể đe dọa tính mạng.
Nếu dị vật sắc nhọn bị mắc kẹt ở hầu họng hoặc thực quản, bệnh nhân thường sẽ nhận biết được sự hiện diện của nó và sẽ tìm kiếm sự trợ giúp y tế ngay lập tức.
Tuy nhiên, nếu dị vật sắc nhọn, mà bệnh nhân không hay biết, có thể đi đến dạ dày, nó có thể xuyên thủng thành dạ dày, ruột non hoặc ruột già tại một thời điểm nào đó, gây ra các triệu chứng không điển hình và khó lường.
Điều này thường dẫn đến sự chậm trễ nghiêm trọng trong chẩn đoán và thậm chí có thể gây tử vong.
Bảng này chứa các điểm chính trong tiền sử bệnh của bệnh nhân.
Các dị vật bị nuốt thường là xương cá hoặc xương gia cầm, que gỗ như tăm xỉa răng và tăm cocktail.
Bệnh nhân hầu như không bao giờ nhớ việc đã nuốt phải, và thậm chí tỏ ra không tin khi được thông báo về chẩn đoán.
Độ tuổi trung bình là 60 tuổi và nhiều bệnh nhân có sử dụng hàm răng giả.
Bệnh nhân bị thủng ruột non hoặc ruột già thường có tiền sử phẫu thuật mở bụng (laparotomy) trước đó.
Dị vật gây thủng ở dạ dày và ruột hiếm khi được nghĩ đến trên lâm sàng, và ngày càng được phát hiện nhiều hơn nhờ siêu âm và CT, do đó bác sĩ chẩn đoán hình ảnh đóng vai trò then chốt trong việc phát hiện ban đầu cũng như hướng dẫn điều trị xâm lấn tối thiểu.
Bảng này chứa các điểm chính về các dấu hiệu lâm sàng, siêu âm và CT.
Đau có tính chất thay đổi và không điển hình.
CRP thường tăng nhanh trong vòng 24 giờ đầu.
Thủng dạ dày luôn xảy ra ở vùng tiền môn vị.
Áp xe có thể xuất hiện trong khoang phúc mạc, thành bụng, cơ chậu-thắt lưng (iliopsoas) và gan.
Bản thân dị vật có thể khá kín đáo và dễ bị bỏ sót.
Điều này đòi hỏi sự cảnh giác và tìm kiếm chủ động trên phim chụp CT.
Bảng này chứa các điểm chính về phương pháp điều trị.
Khi có thể, lấy dị vật qua nội soi là lựa chọn tốt nhất, tiếp theo là phẫu thuật xâm lấn tối thiểu được hướng dẫn bởi các kết quả siêu âm và CT.
Áp xe có thể được dẫn lưu qua da, hoặc được phẫu thuật lấy bỏ cùng với việc loại bỏ dị vật.
Trong mọi trường hợp, kháng sinh là bắt buộc.
Kháng sinh đơn thuần có thể là phương pháp điều trị dứt điểm, đặc biệt trong trường hợp xương cá nhỏ và sau khi dẫn lưu áp xe thành công.
Hiếm gặp hơn, dị vật sắc nhọn có thể gây thủng cục bộ nhưng vẫn tự thoát ra ngoài theo đường tự nhiên của ruột.
Hiện tượng này được gọi là “pinprick-and-pass” (thủng-và-thoát).
Dịch tễ học và sinh lý bệnh
Vẫn chưa rõ tần suất thực sự của việc các dị vật sắc nhọn gây thủng dạ dày và ruột trong quá trình di chuyển qua đường tiêu hóa.
Nhiều khả năng phần lớn xương cá cuối cùng được thải ra theo phân mà không gây ra vấn đề gì.
Khi được tìm kiếm có chủ đích, việc phát hiện các xương tăng tỷ trọng (mũi tên) trong lòng ruột không phải là hiếm gặp, như ở ba bệnh nhân không có triệu chứng này.
Các dị vật sắc nhọn có khả năng xuyên thủng thường gặp nhất là xương cá, xương gà và que gỗ như tăm xỉa răng hoặc tăm cocktail.
Đại đa số bệnh nhân không nhớ mình đã nuốt phải vật thể đó, và khi được đối chiếu với dị vật sắc nhọn, họ thường tỏ ra hết sức ngạc nhiên và không tin vào điều đó.
Nhiều bệnh nhân đeo hàm giả, khiến vòm miệng của họ kém nhạy cảm hơn.
Không phải lúc nào cũng có thể phân biệt xương với que gỗ trên CT, nhưng xương cá thường tăng tỷ trọng rõ và có hình dạng cong, trong khi que gỗ ít tăng tỷ trọng hơn và có hình dạng thẳng hơn.
Một nửa số bệnh nhân bị thủng ruột non có tiền sử phẫu thuật bụng trước đó.
Các dải dính gây gập góc cục bộ các quai ruột, cản trở dị vật sắc nhọn “vượt qua góc cua” đó.
Khi một vật sắc nhọn xuyên qua thành dạ dày hoặc ruột, mạc nối và mạc treo ruột sẽ cố gắng bao bọc lỗ thủng hình thành.
Thường sẽ hình thành áp xe: trong khoang phúc mạc, trong gan, trong thành bụng hoặc trong cơ thắt lưng chậu.
Dị vật có thể nằm bên trong áp xe, nhưng cũng có thể ở ngoại vi của nó. Đôi khi, dị vật có thể di chuyển đáng kể.
Một phần ba số dị vật sắc nhọn gây thủng nằm trong tầm với của nội soi dạ dày hoặc nội soi đại tràng.
Đây rõ ràng là lựa chọn tốt nhất cho bệnh nhân.
Bệnh nhân nữ 59 tuổi với cơn đau thượng vị không điển hình kéo dài hai ngày.
Siêu âm phát hiện dày thành đáng kể vùng hang vị trước môn vị, trong đó có cấu trúc tăng âm, dạng cong (đầu mũi tên), nghi ngờ xương cá.
CT xác nhận chẩn đoán.
Lưu ý rằng xương cá (mũi tên) có thể dễ dàng bị bỏ sót nếu chỉ xem trên mặt phẳng cắt coronal của CT.
Bệnh nhân hồi phục tốt sau khi lấy dị vật qua nội soi.
Siêu âm và CT cho thấy xương cá xuyên thủng thành dạ dày ngay trước môn vị.
Khi nội soi dạ dày không tìm thấy xương cá, mà chỉ thấy phù nề niêm mạc cục bộ với loét trung tâm (mũi tên).
Việc đưa sâu dụng cụ kẹp lớn vào vùng này cuối cùng đã thành công trong việc gắp được xương cá.
Bệnh nhân nữ 74 tuổi nhập viện với đau bụng dưới sâu kéo dài 3 tuần. Xét nghiệm: bạch cầu 15, CRP 150. Bệnh nhân có tiền sử nhiều lần phẫu thuật phụ khoa.
CT được thực hiện và phát hiện một dị vật dạng xương, với cả hai đầu đều có vẻ xuyên thủng đại tràng sigma.
Siêu âm qua đường âm đạo xác nhận dị vật đi xuyên qua lòng đại tràng sigma, do đó có thể lấy dị vật qua nội soi đại tràng.
Trong quá trình nội soi, xương gà phải được bẻ làm hai phần để lấy ra an toàn. Bệnh nhân hồi phục tốt với sự hỗ trợ của kháng sinh.
Nếu dị vật không thể tiếp cận bằng nội soi nhưng phẫu thuật viên có thể tiếp cận thuận lợi, về nguyên tắc cần chỉ định phẫu thuật lấy dị vật.
Bệnh nhân nam 33 tuổi này (có tiền sử cắt đoạn ruột lúc 4 tuổi) nhập viện với đau thượng vị và CRP 155. Siêu âm và CT xác nhận cấu trúc dạng xương (mũi tên) xuyên thủng quai ruột non có dính.
Qua đường mổ nhỏ (mini-laparotomy), một mảnh xương sắc dài 6 cm đã được lấy ra. Bệnh nhân đã ăn vịt Bắc Kinh hai ngày trước đó.
Bệnh nhân nam 83 tuổi còn khỏe mạnh nhập viện với đau bụng trên cấp tính và CRP 90. CT phát hiện cấu trúc dạng xương mắc kẹt trong hỗng tràng. Sau 24 giờ điều trị bảo tồn bằng kháng sinh, cơn đau không giảm và CRP tăng lên 230.
Trong phẫu thuật, một mảnh xương sắc nhọn gây thủng đã được lấy ra dễ dàng qua một đường rạch nhỏ trên hỗng tràng, không cần cắt đoạn ruột.
Bệnh nhân hồi phục nhanh chóng và hiện tại, mười một năm sau, ở tuổi 94, ông vẫn trong tình trạng sức khỏe hoàn hảo. Ông vẫn không thể tin rằng mình đã từng nuốt phải một mảnh xương lớn như vậy.
Trong trường hợp áp xe ở vị trí sâu như áp xe gan, chỉ định dẫn lưu qua da kết hợp với kháng sinh dài ngày. Ở một số bệnh nhân, đây có thể là phương pháp điều trị dứt điểm.
Bệnh nhân nữ 61 tuổi này nhập viện với áp xe gan lớn liên quan đến xương cá. Bệnh nhân béo phì và có nhiều chống chỉ định khác đối với phẫu thuật.
Sau nhiều lần dẫn lưu qua da và mười tuần dùng kháng sinh, bệnh nhân cuối cùng đã hồi phục, với xương cá vẫn còn tại chỗ, rõ ràng đã được bao bọc.
Hiện tại, mười năm sau, bệnh nhân vẫn ổn định.
Đôi khi, việc tìm kiếm dị vật trong phẫu thuật nội soi hoặc mổ mở có thể rất khó khăn.
Bệnh nhân này nhập viện với đau bụng trên và CRP 245. Siêu âm và CT phát hiện một dị vật thẳng, hơi tăng tỷ trọng, có thể là tăm cocktail (đầu mũi tên).
Trong phẫu thuật hai ngày sau, áp xe gan đã được dẫn lưu, nhưng không tìm thấy dị vật. Sau đó bệnh nhân đáp ứng tốt với kháng sinh.
Vào ngày thứ 15, CT cho thấy áp xe đang thoái triển với dị vật (đầu mũi tên) vẫn còn tại chỗ. Cuối cùng, bệnh nhân hồi phục với liệu trình kháng sinh dài ngày.
Que gỗ đôi khi có thể đồng tỷ trọng với thành ruột hoặc mô gan mà chúng xuyên qua, và do đó có thể khó hoặc không nhìn thấy được trên CT. Trong những trường hợp này, siêu âm tập trung có thể hữu ích.
Ở bệnh nhân A, hình ảnh CT cho thấy bóng khí, thâm nhiễm mỡ và dày thành ruột cục bộ, gợi ý thủng cục bộ, nhưng không thấy dị vật.
Siêu âm ngay lập tức vùng này đã phát hiện rõ ràng một dị vật sắc nhọn (mũi tên) xuyên qua thành ruột (b.) vào lớp mỡ xung quanh đang viêm (*).
Ở bệnh nhân B, dày thành hang vị và áp xe gan lân cận gợi ý dị vật gây thủng, tuy nhiên không thể xác định được trên CT.
Siêu âm, được thực hiện với sự hiểu biết về kết quả CT, đã dễ dàng phát hiện dị vật, rõ ràng là đồng tỷ trọng. (st. = dạ dày)
Thường không hình thành áp xe và xương cá, sau khi di chuyển, sẽ được bao bọc lại. Kháng sinh có thể hỗ trợ quá trình bao bọc này.
Bệnh nhân nữ 48 tuổi này nhập viện với đau quanh rốn dữ dội kéo dài 12 giờ (Xét nghiệm: bạch cầu 15, CRP 7).
Ngày hôm sau cơn đau giảm, nhưng CRP tăng lên 65.
Siêu âm vùng quanh rốn cho thấy dày thành ruột non (b.) dạng phù nề với nhu động bình thường.
Có một ổ dịch nhỏ (f.) và viêm mạc treo ruột tăng âm, không nén được (*).
CT tiếp theo xác nhận dày thành ruột non (b.) và thâm nhiễm mỡ (*) trong mạc treo ruột. Ở rãnh cạnh đại tràng trái, phát hiện một xương cá (mũi tên).
Rõ ràng xương cá, sau khi xuyên thủng hỗng tràng, đã di chuyển đến vị trí đó.
Thăm dò nội soi ổ bụng tiếp theo không thể xác định được xương cá.
Bệnh nhân hồi phục tốt với kháng sinh.
CT thực hiện vì lý do khác 18 tháng sau cho thấy xương cá di chuyển nhẹ, rõ ràng đã được bao bọc tốt.
Bệnh nhân vẫn ổn định tám năm sau.
Trong trường hợp triệu chứng tương đối nhẹ ở bệnh nhân có xương cá nhỏ gây thủng mà không có áp xe, điều trị kháng sinh ban đầu có thể là lựa chọn đầu tiên tốt.
Ba bệnh nhân khác nhau này đều hồi phục tốt chỉ với kháng sinh.
Đôi khi thiên nhiên rất nhân từ.
Bệnh nhân nữ 72 tuổi này nhập viện với đau thượng vị cấp tính và CRP 180, do xương cá xuyên thủng dạ dày.
Chỉ dùng thuốc ức chế bơm proton.
Các triệu chứng nhanh chóng thuyên giảm và CRP trở về bình thường sau ba ngày.
Bệnh nhân hồi phục hoàn toàn và 11 năm sau vẫn ổn định.
Hai bệnh nhân khác nhau với xương cá được bao bọc trong thành hang vị, phát hiện tình cờ trên CT thực hiện vì lý do khác.
Cả hai bệnh nhân đều không nhớ có giai đoạn đau thượng vị nào và hình ảnh CT không thay đổi trong nhiều năm.
Trong trường hợp áp xe thành bụng, có thể phẫu thuật để dẫn lưu áp xe và lấy dị vật.
Ở bệnh nhân này, chỉ cần một đường rạch nhỏ quanh rốn là đủ để dẫn lưu mủ và lấy xương cá.
Bệnh nhân 58 tuổi này nhập
Các bệnh lý gây thủng đường tiêu hóa
Nguyên nhân gây thủng
Khi siêu âm hoặc CT phát hiện dày thành ruột kết hợp với thâm nhiễm mỡ, hình ảnh khí tự do và/hoặc hình thành ổ áp-xe, nguyên nhân cơ bản không phải lúc nào cũng rõ ràng.
Từ gợi nhớ PSI-ABCD có thể hữu ích:
- Loét dạ dày tá tràng (Peptic ulcer)
- Dị vật sắc nhọn (Sharp foreign body)
- Thiếu máu ruột (Ischemic bowel)
- Viêm ruột thừa (Appendicitis)
- Ung thư đại tràng (Bowel carcinoma)
- Bệnh Crohn (Crohn’s disease)
- Viêm túi thừa (Diverticulitis)
Trong bảng, phân loại sao biểu thị tần suất của các tình trạng có khả năng gây thủng này.
Trong 99,99% trường hợp, một trong bảy tình trạng này là nguyên nhân gây thủng hoặc thủng được bao bọc.
Tại bệnh viện chúng tôi, số lượng trường hợp dị vật sắc nhọn gây thủng tương đối nhiều, khoảng 3-4 ca mỗi năm.
Điều này một phần được giải thích bởi dân số nhập cư đông đảo, có thói quen ăn các loài cá đặc trưng.
Đặc biệt, người Suriname chiếm 30% bệnh nhân của chúng tôi nhưng lại chịu trách nhiệm cho 70% các trường hợp thủng do xương cá.
Thủng vi điểm và tự thoát (Pinprick-and-pass)
Một dị vật sắc nhọn có thể gây thủng, nhưng sau đó vẫn có thể tự thoát ra ngoài theo phân một cách bình thường (“thủng vi điểm và tự thoát”).
Bệnh nhân nam 85 tuổi này nhập viện với đau khu trú dữ dội, viêm phúc mạc khu trú và CRP 200, lâm sàng nghi ngờ viêm ruột thừa.
Siêu âm cho thấy một vùng nhỏ khu trú gồm mỡ tăng âm bị viêm (đầu mũi tên), chứa một ít dịch (*) và một phản âm khó lý giải (mũi tên trắng).
Chẩn đoán siêu âm dự kiến là viêm phần phụ mạc nối với vùng xuất huyết trung tâm nhỏ.
CT xác nhận thâm nhiễm mỡ khu trú và phát hiện thêm một bóng khí cũng như dày thành nhẹ của một quai ruột non lân cận.
Áp dụng từ gợi nhớ PSI-ABCD, tất cả các nguyên nhân đều được loại trừ, ngoại trừ dị vật sắc nhọn.
Sau khi tìm kiếm có chủ đích, một xương cá được phát hiện tại manh tràng (mũi tên xanh lá trên CT).
Rõ ràng, xương cá này đã gây ra thủng, và sau đó được đẩy đi bởi nội dung ruột non. Bệnh nhân được điều trị bằng kháng sinh đơn thuần và hồi phục hoàn toàn.
Các ca lâm sàng minh họa
Bệnh nhân nữ 37 tuổi với triệu chứng đau thượng vị tiến triển trong 4 ngày.
Siêu âm phát hiện một cấu trúc đường cong phản âm (đầu mũi tên) kéo dài từ dạ dày (st.) vào tụy đang sưng nề, nghi ngờ là xương cá. (gb=túi mật).
CT không tiêm thuốc cản quang xác nhận có xương cá cắm vào tụy.
Khi nội soi dạ dày, không thấy xương cá, chỉ thấy một khiếm khuyết niêm mạc nhỏ tạo ra một số sợi fibrin.
Chúng tôi cho rằng đây là điểm xương cá đã xuyên qua, trong khi phần đầu còn lại của xương cá bị “chôn vùi” trong lớp niêm mạc phù nề phản ứng của thành sau dạ dày (xem hình vẽ).
Được khích lệ bởi thông tin này, bác sĩ nội soi đã thực hiện thao tác thăm dò sâu bằng kẹp lớn, và cuối cùng đã thành công.
Bệnh nhân hồi phục hoàn toàn và cho biết đã ăn cá “jarabaka” một tuần trước đó, một loại cá của Suriname, nổi tiếng với hương vị thơm ngon và xương sắc nhọn.
Bệnh nhân nam 81 tuổi với đau thượng vị tiến triển trong 24 giờ.
Siêu âm phát hiện phình động mạch chủ kích thước 5,2 cm.
CT scan ngay lập tức loại trừ vỡ phình mạch, tuy nhiên ghi nhận một số hình ảnh mờ mỡ tinh tế ở phía trước tá tràng xung quanh một cấu trúc nhỏ tăng tỷ trọng.
CT phát hiện xương cá (mũi tên) trong tá tràng, xuyên thủng thành bụng của tá tràng.
Khi nội soi dạ dày, xương cá được nhận diện dễ dàng và lấy ra.
Lưu ý màu xanh lá của xương cá do sắc tố mật.
Khi được thông báo kết quả, bệnh nhân không thể tin rằng mình đã nuốt phải một chiếc xương cá lớn như vậy.
Bệnh nhân nam 50 tuổi với đau hố chậu trái và CRP 21, nghi ngờ viêm túi thừa.
Siêu âm ban đầu cho thấy dày thành đại tràng sigma, mỡ viêm (*) và sỏi phân trong túi thừa (đầu mũi tên trắng).
Quan sát kỹ hơn vùng có mỡ viêm nhiều nhất, không thể ép xẹp (đầu mũi tên xanh và *), phát hiện một dị vật (mũi tên).
CT không tiêm thuốc cản quang xác nhận có mảnh xương và hình ảnh mờ mỡ tinh tế (*) xung quanh đại tràng sigma.
Lấy dị vật qua nội soi tương đối dễ dàng.
Bệnh nhân nữ 60 tuổi với sốt cao và nghi ngờ lâm sàng là viêm tụy.
CT scan cho thấy áp xe ở thùy vuông gan, chứa xương cá di chuyển từ dạ dày vào gan.
Siêu âm nội soi xác nhận xương cá nằm hoàn toàn trong áp xe gan (mũi tên), do đó không thể lấy qua nội soi.
Trong phẫu thuật, áp xe được dẫn lưu và xương cá được lấy ra.
Bệnh nhân nam 75 tuổi với nghi ngờ lâm sàng áp xe cơ thắt lưng chậu.
CT xác nhận áp xe và xác định một dị vật sắc nhọn thẳng, hơi tăng tỷ trọng, có vẻ đã di chuyển từ ruột non vào cơ chậu.
Hình dạng và tỷ trọng gợi ý đây là que gỗ hơn là xương cá.
Bằng phẫu thuật xâm lấn tối thiểu, cả mủ và que gỗ đều được lấy ra.
Bệnh nhân có hàm răng giả, tiền sử cắt ruột thừa và có thói quen “gạt” thịt khỏi que xiên bằng nĩa.
Bệnh nhân nam 53 tuổi nhập viện với khối đau hố chậu trái và CRP 173, nghi ngờ viêm túi thừa.
Bệnh nhân có tiền sử cắt thận trái 20 năm trước.
Siêu âm phát hiện áp xe thành bụng chứa một cấu trúc mỏng, đường cong (mũi tên).
CT không và có tiêm thuốc cản quang tĩnh mạch xác nhận xương cá (mũi tên) trong áp xe thành bụng có ranh giới không rõ ràng.
Lưu ý rằng xương cá có thể dễ dàng bị bỏ sót nếu chỉ chụp CT có tiêm thuốc cản quang tĩnh mạch.
Vị trí áp xe và xương cá được đánh dấu trên da.
Chỉ với một đường rạch rất nhỏ, mủ và xương cá đã được lấy ra. Hồi phục không biến chứng.
Bệnh nhân nam 57 tuổi (tiền sử cắt ruột thừa) với nghi ngờ viêm túi thừa.
CT cho thấy dày thành đại tràng sigma (s.) và một khối không rõ ràng ở phía trái.
Tại thời điểm này, đường tăng âm nhỏ (mũi tên) đã bị bỏ sót.
Chẩn đoán CT là viêm túi thừa đại tràng sigma hoặc ác tính đại tràng sigma.
Nội soi đại tràng không tiếp cận được vùng này.
Trên CT lặp lại một tuần sau, chúng tôi may mắn khi dị vật sắc nhọn thẳng và hơi tăng âm (mũi tên) lần này hiện ra toàn bộ chiều dài trên CT mặt phẳng coronal.
Trong phẫu thuật, một phần đại tràng sigma được cắt bỏ cùng với một khối viêm lớn, chứa que tăm cocktail bằng gỗ là nguyên nhân gây bệnh.
Một hậu môn nhân tạo tạm thời đã được tạo ra.
Bệnh nhân tỏ ra không tin và kiên quyết phủ nhận việc đã nuốt phải que đó.
Trong một thủ thuật nội nha tại phòng khám nha khoa, bệnh nhân nam 46 tuổi vô tình nuốt phải một “dũa nội nha”.
Bệnh nhân không có triệu chứng bụng, nhưng trở nên lo lắng khi sau một tuần vẫn không tìm thấy dụng cụ này trong phân.
CT không tiêm thuốc cản quang xác nhận thủng quai hỗng tràng, với hình ảnh mờ mỡ xung quanh rất ít.
Trong phẫu thuật, một đoạn hỗng tràng được cắt bỏ cùng với dũa nội nha.
Bệnh nhân nữ người Suriname trẻ (31 tuổi) với đau hố chậu trái 3 tuần và CRP 55, nghi ngờ viêm phần phụ hoặc viêm túi thừa.
Tiền sử vỡ tử cung.
Siêu âm cho thấy khối giảm âm bên trái tử cung (u.) nghi ngờ áp xe vòi trứng-buồng trứng (TOA).
Ở ngoại vi thấy một phản âm mỏng, đường cong (mũi tên).
Siêu âm qua đường âm đạo xác nhận xương cá (mũi tên) trong thành của TOA.
CT không tiêm thuốc cản quang cho thấy TOA có liên quan mật thiết với đại tràng sigma, vốn cũng có dày thành khu trú.
Trong phẫu thuật, TOA và xương cá dính chặt vào đại tràng sigma đã được lấy ra.
Rõ ràng, xương cá sau khi xuyên thủng đại tràng sigma đã di chuyển vào buồng trứng trái, gây ra TOA.
Lưu ý màu xanh lá của xương cá, có thể do sắc tố mật.
Bệnh nhân nữ béo phì 80 tuổi với nghi ngờ lâm sàng mạnh về viêm ruột thừa.
Tiền sử cắt túi mật.
Xét nghiệm: bạch cầu 21, CRP 125.
Siêu âm cho thấy mỡ viêm (*) xung quanh quai ruột non phù nề (b.), chứa một cấu trúc phản âm bất thường (mũi tên).
Hình ảnh siêu âm trên hai mặt phẳng vuông góc gợi ý dị vật này có bản chất dẹt.
CT xác nhận dày thành ruột non, hình ảnh mờ mỡ và khí ngoài lòng ruột.
Quan sát kỹ hơn trên mặt phẳng axial và coronal của CT, phát hiện một cấu trúc dẹt hai lớp, hơi tăng tỷ trọng (mũi tên) nằm trong lòng ruột, nguồn gốc chưa rõ.
Phẫu thuật phát hiện tổn thương loét khu trú ruột non do một mảnh vỏ rau quả sắc cạnh.
Sau phẫu thuật, bệnh nhân nhận ra đây là vỏ của quả xoài xanh, được dùng trong món mứt xoài tự làm của bà.
Bệnh nhân nam 79 tuổi, đang nằm viện hai ngày vì nhồi máu cơ tim, đột ngột xuất hiện đau hố chậu phải và CRP 70, nghi ngờ viêm ruột thừa.
Bệnh nhân đang được cách ly vì nghi ngờ nhiễm MRSA.
Siêu âm cho thấy ruột thừa bình thường kích thước 4 mm và dày thành hồi tràng đoạn cuối, xung quanh là mỡ viêm (*).
Cạnh hồi tràng quan sát thấy một bóng khí có thể có (mũi tên xanh).
Trong lòng hồi tràng, phát hiện một cấu trúc phản âm dạng tuyến tính (đầu mũi tên).
Hình ảnh trên nhiều mặt phẳng gợi ý đây là dị vật dẹt.
Ở một đầu, một cạnh sắc rõ ràng (mũi tên trắng) nhô ra vào mỡ viêm xung quanh (*).
CT axial xác nhận các phát hiện trên siêu âm và xác định một dị vật có hình dạng bất thường.